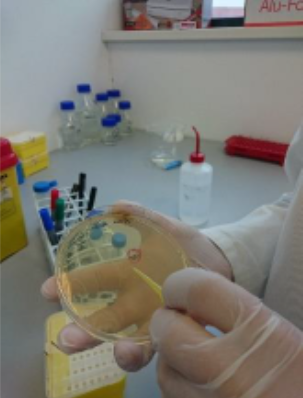

Producerea de alergene recombinate din polenul de ambrozia în cadrul proiectului INSPIRED
În cadrul proiectului INSPIRED (Strategii inovative pentru prevenția, diagnosticul și terapia afecțiunilor respiratorii induse de polenul de ambrozia) s-a identificat profilul de sensibilizare IgE al pacienților alergici la polenul de ambrozia (Ambrosia artemisiifolia).

Pe baza acestui profil au fost identificate și caracterizate alergenele din polenul de ambrozia (Ambrosia artemisiifolia). Pentru a efectua caracterizarea, s-a identificat secvența proteică a acestor alergene din bazele de date (allergen.org) și s-a realizat un construct pentru expresia acestora în celule procariote, Escherichia coli, și eucariote, Spodoptera frugiperda (Sf9).

Sistemul de expresie a fost ales în funcție de complexitatea structurală a proteinei.
Constructul codificând proteina de interes a fost inserat în genomul celulelor procariote prin administrarea unui șoc termic. Apoi s-a adăugat un factor de transcripție pentru a induce expresia proteică. Pentru a produce proteinele în celule de insecte, constructul genic a fost introdus în celule E. coli pentru amplificare și obținerea unui bacmid cu secvența de interes. Acesta a fost apoi folosit pentru transfecția celulelor de insecte, amplificarea stocului baculoviral și producția de proteine. Proteinele au fost apoi izolate și purificate prin cromatografie de afinitate. Puritatea a fost verificată pe SDS-PAGE. Producția mai detaliată a proteinelor se regăsește în Zbircea et al. 2023, Tămaș et al. 2023, Grijincu et al. 2023.

Aceste proteine au fost incluse într-un brevet pentru dezvoltarea unui kit de diagnostic al alergiei la polenul de ambrozia. Ele au fost folosite și pentru a obține anticorpi alergen-specifici care s-a folosit într-un al doilea brevet pentru detectarea alergenelor din polenul de ambrozia în mediu sau din extractele alergenice pentru diagnostic sau imunoterapie.
Brevete rezultate în urma proiectului INSPIRED
Panaitescu C., Chen KW., Păunescu V., Buzan RM.
„Kit și metodă de utilizare pentru diagnosticul alergiei l la ambrozie”, nr.A /00615 /2020, data de depozit 30/09/2020, Oficiul de Stat pentru Invenții și Mărci (OSIM), Direcția de brevete de invenție și informații tehnologice.
Panaitescu C.,Chen KW., Buzan RM., Grijincu M., Zbircea LE.,Tamas TP., Haidar L.,Tanasie G., Hutu I.
„Kit de testare cu anticorpi alergen-specifici pentru detecția și cuantificarea alergenelor din polenul de Ambrozia din mediu și din extracte alergenice diagnostice/terapeutice”, nr. A/ 00759/ 2020, data de depozit 19/11/2020, Oficiul de Stat pentru Invenții și Mărci (OSIM), Direcția de brevete de invenție și informații tehnologice.
Publicații rezultate în urma proiectului INSPIRED
- Chen et al. 2018 - Ragweed Pollen Allergy: Burden, Characteristics, and Management of an Imported Allergen Source in Europe - Impact factor 2.932 - https://karger.com/iaa/article/176/3-4/163/168362
- Panaitescu et al. 2022 - Precision medicine in the allergy clinic: the application of component resolved diagnosis - Impact Factor: 4.47 - https://www.tandfonline.com/doi/full/10.1080/1744666X.2022.2034501
- Bumbăcea et al. 2022 - Mechanisms of allergen immunotherapy supporting its disease-modifying effect - Impact Factor: 4.19 - https://www.futuremedicine.com/doi/abs/10.2217/imt-2021-0325
- Marusciac et al. 2021 - Symptom patterns and comparison of diagnostic methods in ragweed pollen allergy - Impact factor 2.751 - https://www.spandidos-publications.com/10.3892/etm.2021.9957
- Buzan et al. 2022 - Complex IgE sensitization patterns in ragweed allergic patients: Implications for diagnosis and specific immunotherapy - Impact Factor: 5.657 - https://onlinelibrary.wiley.com/doi/full/10.1002/clt2.12179
- Zbircea et al. 2023 - Relationship between IgE Levels Specific for Ragweed Pollen Extract, Amb a 1 and Cross-Reactive Allergen Molecules - Impact factor 6.208 - https://www.mdpi.com/1422-0067/24/4/4040
- Tamaș et al. 2023 - Ragweed Major Allergen Amb a 11 Recombinant Production and Clinical Implications - Impact Factor: 6.064 - https://www.mdpi.com/2218-273X/13/1/182
- Grijincu et al. 2023 - Physicochemical and immunological characterization of Amb a 12, a novel ragweed (Ambrosia artemisiifolia) pollen allergen - Impact factor 4.174 - https://www.sciencedirect.com/science/article/pii/S0161589023000548
Rezultate acestei cercetări au fost și vor fi incluse în următoarele teze de doctorat sub coordonarea doamnei prof. univ. dr. Panaitescu Carmen:
| Nume Prenume | Titlu teză |
|---|---|
| Tamaș Tudor Paul | Alergenul major Amb a 11 din polenul de ambrozia (Ambrosia artemisiifolia): expresie in sistem procariot si eucariot, aspecte imunoproteomice și corelatii clinice |
| Buzan Maria Roxana | Caracterizarea imunoproteomică a alergenelor recombinate din polenul de Ambrosia artemisiifolia |
| Zbîrcea Lauriana-Eunice | Evaluarea reacției de reactivitate încrucișată și testarea relevanței clinice a unor alergene din Ambrosia artemisiifolia |
| Grijincu Manuela | Caracterizarea unei noi proteine alergenice din familia liazelor din polenul de ambrozia (Ambrosia artemisiifolia) și evaluarea relevanței clinice a acesteia |
| Zimbru Razvan | Evaluarea markerilor inflamației alergice prin metode noninvazive |